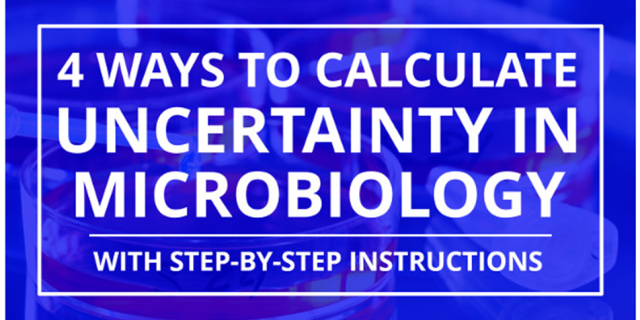

تحليل سناريو
تحليل سناريو بررسي اجمالي تحليل سناريو تحليل سناريو نامي است كه به روش توصيفي داده شده است كه چگونگي تغييرات
تكنيك ساختارمند «چه می شود اگر» (SWIFT)
تكنيك ساختارمند «چه می شود اگر» (SWIFT) بررسي اجمالي SWIFT در اصل به عنوان جايگزيني ساده براي HAZOP ايجاد شده
ارزيابی سميت
ارزيابی سميت بررسي اجمالی ارزيابی سميت ، ارزيابي ريسك محيط زيست كه در اينجا استفاده مي شود، فرآيندي است كه
اشتباهات عدم قطعیت
اشتباهات عدم قطعیت اشتباهات عدم قطعیت در محاسبه آن 10 اشتباه وحشتناکی که باید از آنها اجتناب کنید مقدمه محاسبه
4 روش برای محاسبه عدم قطعیت در آزمایشگاه های میکروبیولوژی
4 روش برای محاسبه عدم قطعیت در آزمایشگاه های میکروبیولوژی معرفی محاسبه عدم قطعیت در آزمایشگاه های میکروبیولوژی به یک
مطالعه خطر و عملكرد HAZOP
مطالعه خطر و عملكرد HAZOP بررسي اجمالي HAZOP نام مخفف از مطالعه خطر و عملكرد است و بررسي منظم و
تحليل خطر و نقاط كنترل بحرانی (HACCP)
تحليل خطر و نقاط كنترل بحرانی (HACCP) بررسي اجمالی تحلیل خطر و نقاط كنترل بحرانی (HACCP) ساختاري براي شناسايي مخاطره
تحليل خطر اوليه (PHA)
تحليل خطر اوليه (PHA) بررسي اجمالي تحليل خطر اوليه روش تحليل ساده قياسي است كه هدف آن شناسايي مخاطرات و

با درود و احترام؛ جناب مهندس در مورد mpu و نحوه یافتن ضریب آن هم (f) لطف می کنید مطلب…
This is a wonderful article, Given so much info in it, These type of articles keeps the users interest in…